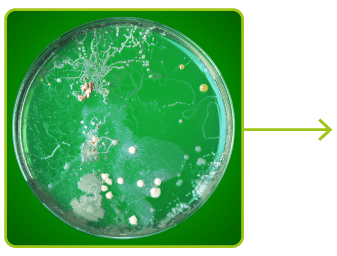

Aplicação de ozônio em bebidas
Continue lendo
Aplicação de ozônio em carnes
Continue lendo
Aplicação de ozônio em ovos
Continue lendo
Aplicação de ozônio em queijos
Continue lendo
Degradação de agrotóxicos com ozônio
Continue lendo
Efeito germicida
Continue lendo
Efeitos sobre o metabolismo
Continue lendo
Efeitos sobre odores
Continue lendo
Ozônio para desinfetar e remover odores
Continue lendo
